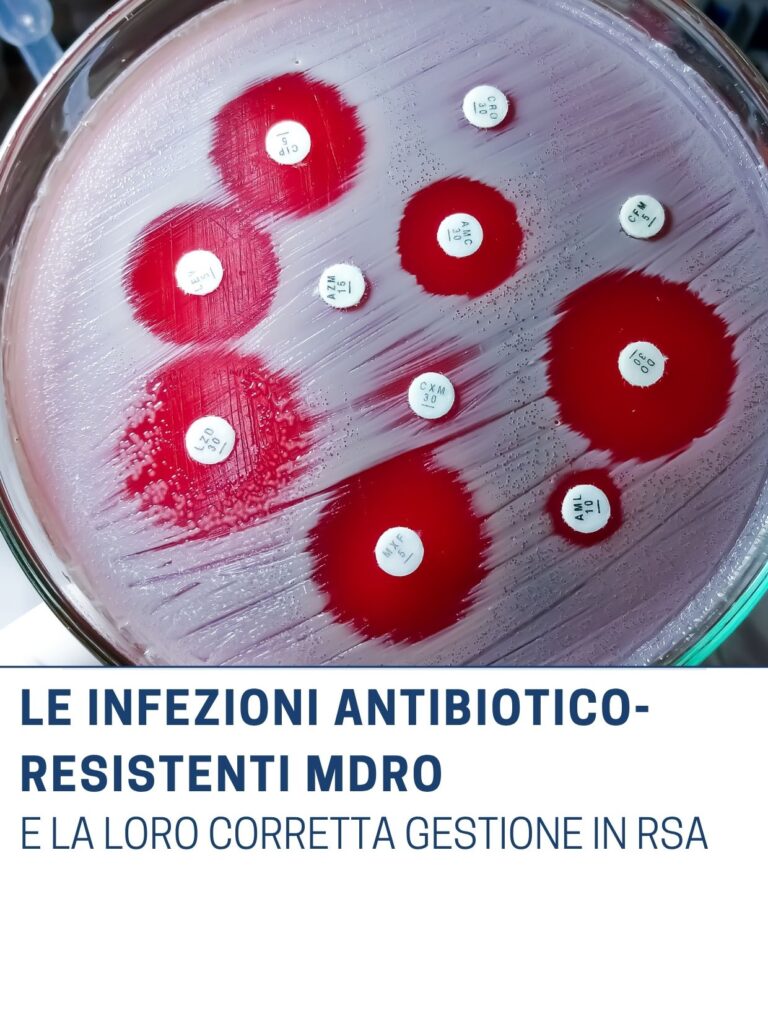

prezzo da 26€ a 15€ sulla base del numero di corsi acquistati e della scontistica spettante
I principali obiettivi del corso sono quelli di mitigare l’incidenza delle infezioni da patogeni trasmissibili nel setting assistenziale delle strutture residenziali e di mantenere livelli elevati di adesione alle buone prassi di prevenzione a cominciare dall’igiene delle mani.
cosa apprenderai:
- conosci il tuo nemico: MDRO
- la catena di responsabilità gestionale
- lo strano caso del dott. Semmelweis
- tipologie di precauzioni
- DPI: focus sul corretto uso dei guanti
- misure operative
- la sanificazione corretta
- emergenze e domande